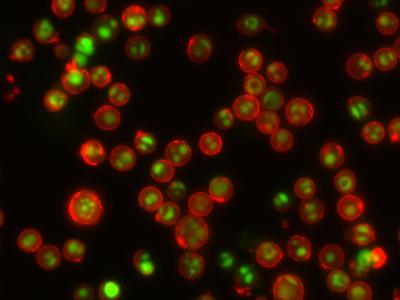

Dual Apoptosis Assay ,Each
$ 674.50
|
|
Details:
Apoptosis Markers^ This kit provides two apoptosis markers, our novel green fluorogenic NucView 488 caspase-3 substrate and red fluorescent CF594-annexin V for detecting phosphatidylserine translocation.
Additional Information
| SKU | 23271821 |
|---|---|
| UOM | EACH |
| UNSPSC | 41106620 |
| Manufacturer Part Number | 30067 |
| Product Dimensions | 10X10X10 Inches |
| Product Weight | 5 |
